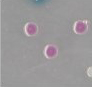
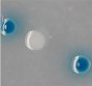

產品介紹
CHROMagar 科瑪嘉 酵素基質呈色培養基
獸醫專用培養基
科瑪嘉 O157 / 科瑪嘉 大腸桿菌
 |
產品說明: 科瑪嘉 CHROMagar O157
科瑪嘉 大腸桿菌
產品編號:EE222
應用於食品和動物樣品中,分離與鑑定大腸桿菌O157。
微生物典型顏色外觀
大腸桿菌O157 → 紫紅色
其他細菌 → 鋼藍色,無色或抑制。 |
| 產品名稱 : 科瑪嘉 O157 / 科瑪嘉 大腸桿菌 |
| ► |
產品外觀 |
| |
|
大腸桿菌O157 → 紫紅色 |
| |
|
其他細菌 → 鋼藍色,無色或抑 |
| ► |
培養基特性 |
| |
1. |
容易檢測:大腸桿菌O157在培養18小時後產生紫紅色菌落,其他大腸桿菌則是藍色。 |
| |
2. |
與SMAC相比,CHROMagar™ E.coli O157具有更高的特異性:
用於檢測大腸桿菌O157的傳統常規的培養基是 Sorbitol MacConkey(SMAC)瓊脂,特異性較差,常出現假陽性菌落(Proteus,E. hermanii等)不易判讀,且長培養時間,顏色常會發生改變。
高靈敏度:大腸桿菌O157 → 89%* |
| |
|
* Sensitivity from scientific study: K.A. Bettelheim, 1998. Reliability of CHROMagar O157 for the detection of enterohaemorrhagic E. coli (EHEC) O157 but not EHEC belonging to other serogroups. J.Appl.Microbiol.85:425-428 |
| ► |
培養基描述 |
|
|
| |
Powder Base |
Total ................................................................................ 29.2 g/L
Agar ................................................................................... 15.0
Peptone and Yeast extract ................................................ 13.0
Chromogenic mix ................................................................ 1.2
Storage at 15/30 °C - pH: 6.9 ± 0.2
Shelf Life ................................................................. > 18 months |
|
| |
Usual Samples |
food, meat trimmings, animal faecal samples |
|
| |
Procedure |
Direct streaking or after an appropriate enrichment step of the sample. Incubation 24 h at 37 °C. |
|
| |
Scientific Publications on this product: available on www.CHROMagar.com
Please read carefully the instructions for use (IFU document) available on
www.CHROMagar.com |
|
| |
Gain flexibility using powder rather than ready to use plates: Use the entire pack, or, just a portion if there is a need for a smaller number of plates. If kept under appropriate storage temperature, CHROMagarTM E.coli O157 has a more than 18 months shelf life. This flexibility is essential to avoid the waste resulting from expired-unused plates.
-Referenced in the Chinese Standard for microbiological examination of food hygiene GB/T 4789.36-2008.
-USDA SOP No.: MDP-QA-03 (Page 1 of 6 Title: Quality Assurance (QA) Controls Revision: 06 Replaces: 04/01/09 Effective: 09/25/09, United States Department of Agriculture,Agricultural Marketing Service, Science & Technology, Microbiological Data Program)
Please refer to our notice and Material Safety data sheet for complete information about the medium.
CHROMagar™, Rambach™, AquaCHROM™ are trademarks created by Dr. A. Rambach.
Last Update: 21-May-2019
|
| ► |
專注於大腸桿菌O157 |
| |
大腸桿菌( E.coli)是通常在人類腸道和溫血動物中發現的細菌。 大多數大腸桿菌菌株是無害的。 然而,一些菌株,如細胞毒性大腸桿菌( VTEC),也稱為 Shigatoxigenic E. coli(STEC),可引起嚴重的食源性疾病。 腸出血性大腸桿菌( EHEC)是 VTEC的一個子集,可引起人類的嚴重疾病,如溶血性尿毒綜合徵( HUS)。 VTEC已從許多動物的腸道內容物中分離出來,包括牛和羊。 VTEC主要通過食用受污染的食物傳播給人類,但也可以通過處理攜帶這些細菌的動物傳播。 |
| ► |
大腸桿菌O157流行病學問題 |
| |
大腸桿菌血清型 O157:H7或其非運動變體O157:H-是與公共健康相關的最常見的 VTEC血清型。 在美國發生兩次疫情后,其重要性在 1982年得到了認可。 從那時起,全世界已報告超過180次爆發,估計每年有 78,000例 W.H.O感染。
作為典型的 VTEC,大腸桿菌 O157天然存在於家畜的腸內容物中,尤其是牛和羊。 它們在這些動物的糞便中的存在使它們成為食物和水污染的重要來源。 |
 |
| 有興趣請點選 |
 |
參觀選購 |
|
|